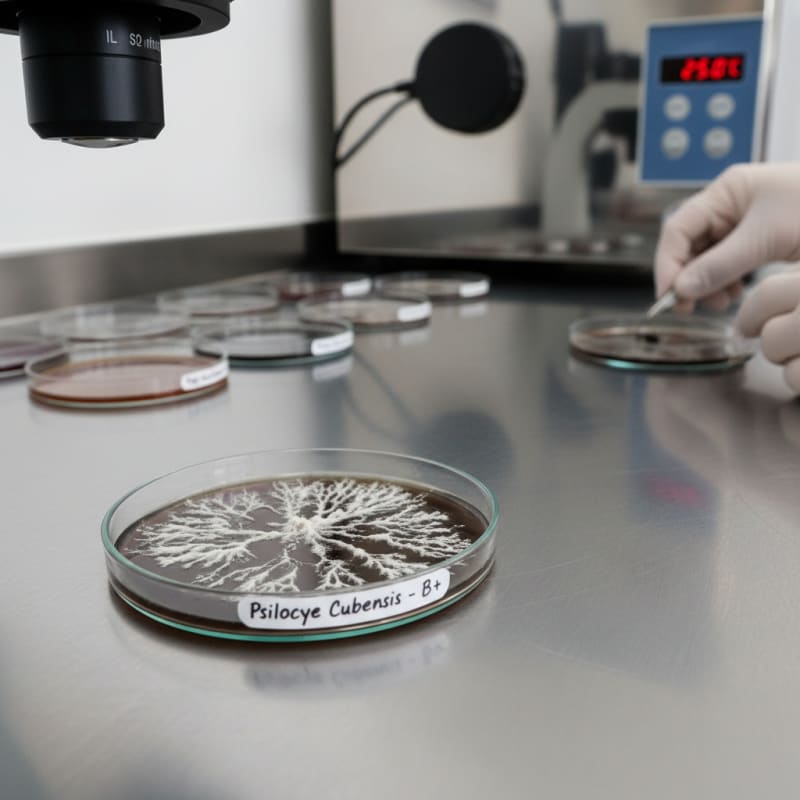
mushroom strains illustration 3

Beginner Guide to Mushroom Strains
Quick Summary
Mushroom strains are cultivated variations within a species. Common Psilocybe cubensis strains include Golden Teacher, Albino Penis Envy, and Bluey Vuitton, which differ in appearance and growth patterns.

Psilocybin mushrooms appear in many different strains and varieties.
These strains often belong to the same species but display different visual characteristics.
What a Mushroom Strain Means
A strain refers to a cultivated variation within a species.
Selective cultivation can produce mushrooms with distinctive cap shapes, colors, or growth patterns. For a broader overview of the species, see what are psilocybin mushrooms.
Common Psilocybe Cubensis Strains
Psilocybe cubensis contains many recognizable strains.
Some well known examples include Golden Teacher, Albino Penis Envy, and Bluey Vuitton.
Although these strains belong to the same species, they can differ visually and genetically.
Why Strains Are Recognized
Cultivators track strains because they may grow differently or produce different yields.
Some strains produce thicker stems or unique cap shapes.
These visual differences help cultivators identify them.
Understanding strain differences is connected to why potency varies across different mushroom products.
ShroomDash Editorial Team
Published 2026-03-08 · 2 min read · Education



